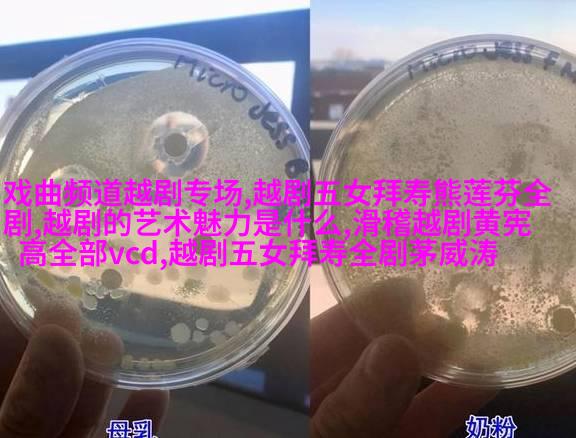

越剧十姐妹寿命考察:历史演义与人生轨迹的对比研究

引言
在中国古代戏曲中,越剧以其独特的艺术风格和深厚的文化底蕴,在民间传承至今。其中最为著名的是“越剧十姐妹”,她们不仅是舞台上的精彩演员,更是历史上的一道亮丽风景。然而,这些姐妹们的人生故事也充满了传奇色彩,其中去世年龄成为我们探讨她们生命轨迹的一个重要线索。
历史背景
越剧源远流长,其起源可以追溯到明清时期。在当时,由于社会经济发展,地方戏曲开始逐渐兴起,而南宋时期的绍兴地区则成为了越剧早期发展的中心之一。这些戏曲作品往往融合了本地特色、民间故事以及生活情感,为后来的越剧奠定了坚实基础。

越剧十姐妹简介
《水浒传》、《西游记》等经典小说中的“越劇十姊妹”并非虚构,它们出现在明末清初绍兴一带,以扮演女扮男、男扮女等各种角色著称。他们以其才华横溢和精湛技艺赢得了观众的心。但遗憾的是,他们的人生并不总是那么幸福美满,有许多因素影响着他们短暂而辉煌的人生。

去世年龄分析
对于这群传奇人物,我们可以通过调查他们去世的时间来窥见一二关于他们生活状态和社会态度。这需要我们参考大量文献资料,从中寻找蛛丝马迹来推断出可能的情况。不过,由于年代久远,以及资料缺失的问题,这项工作并不容易进行,但仍有几个案例值得我们注意。

生活困难与挑战
在那个时代,女性尤其是在文娱界的人士面临着无数困难。她们需要在家庭责任与艺术追求之间找到平衡点,同时还要应对社会偏见和限制。而这些压力可能会对她们的心理健康产生重大影响,甚至导致早逝。此外,那个时代疾病流行、医疗条件差等问题也是一个不可忽视的因素。
社会认可与评价
尽管如此,“越劇十姊妹”的名字却被载入史册,她们的事迹也引发了一定的公众关注。这说明即便是在那个相对封闭且保守的社会里,也有声音倡导艺术家应该得到更好的待遇,并且认为她能够代表一种新的价值观念,即艺术家应该享有一定的尊重和保护权利。
结论及展望
从以上分析可以看出,“越劇十姊妹”的去世年龄是一个复杂多层面的问题,它反映出了当时女性在社会结构中的位置及其所面临的问题。虽然无法完全解开这个谜团,但至少我们能从中学习到一些关于过去文化环境下的女性状况,以及如何通过研究过去来理解现代人的身份认同和价值观念。此外,对于那些致力于保护并推广中国传统文化的小伙伴来说,这样的研究也有助于加强我们的认识,并促进更多人的了解与支持,使这一宝贵遗产能够更加完整地被后人继承下去。


